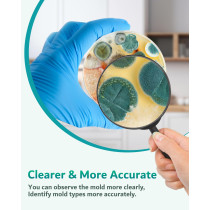
Kit Test Moisissure Maison - 8 Tests HVAC & Air Intérieur

Kit de Test de Moisissure pour la Maison, 8 Tests de Détection pour HVAC, Surfaces & Qualité de l'Air Intérieur
Ce kit de test DIY vous permet d’identifier facilement la moisissure noire chez vous grâce à huit tests précis. Adapté pour l’air ambiant, les surfaces et les systèmes HVAC, il comprend un guide détaillé d’identification ainsi qu’une analyse gratuite en laboratoire pour des résultats fiables et rapides.

Un kit complet conçu pour détecter la moisissure noire dans différents environnements domestiques. Il fournit des tests approfondis qui couvrent la qualité de l’air intérieur, les surfaces contaminées et les systèmes de ventilation. Facile à utiliser, il est idéal pour toute personne souhaitant surveiller la présence de moisissure sans faire appel à un professionnel.

Ce test assure une surveillance complète en analysant non seulement l’air ambiant, mais aussi toutes les surfaces suspects. Il vous aide à mieux comprendre la source des moisissures et à prendre les mesures correctives nécessaires pour protéger votre habitat.
Quatre étapes simples pour tester

Le processus simple en quatre étapes vous guide à travers la collecte des échantillons, l’envoi au laboratoire, et la lecture des résultats. Conçu pour être accessible à tous, même sans expérience technique, ce kit rend l’évaluation de la moisissure rapide et efficace.

Analyse précise de la qualité de l’air intérieur pour identifier la présence invisible de spores de moisissure. Cela permet une intervention rapide afin d’assurer un environnement sain et sécurisé pour votre famille.

Permet d’évaluer les surfaces suspectes directement dans votre espace de vie. Ce test est essentiel pour localiser avec précision les zones affectées, permettant ainsi un nettoyage ciblé et efficace.

Testez et assurez la propreté des conduits de ventilation et de votre système HVAC. Il est crucial pour empêcher la circulation de spores de moisissure dans toute la maison et préserver un air pur.

Spécifiquement conçu pour repérer la moisissure dans les zones où vivent vos animaux, ce test aide à maintenir un environnement propre et sain, réduisant les risques d’allergies ou d’affections respiratoires.
Analyse facile et intuitive à domicile

La collecte et l’analyse en toute simplicité avec un guide clair accompagné d’un support gratuit en laboratoire. Vous obtenez des résultats clairs et fiables, vous aidant à garder votre maison saine sans stress ni complications techniques.

Contient tout le nécessaire pour une détection minutieuse, des outils de prélèvement aux instructions détaillées. Une solution économique et accessible pour surveiller la qualité de votre environnement intérieur.

Spécifiquement formulé pour identifier la moisissure noire, ce kit vous donne la confiance nécessaire pour diagnostiquer les risques avant qu'ils ne deviennent un problème majeur pour votre santé ou votre propriété.

Chaque test est conçu pour fournir une analyse approfondie et précise, aidant à identifier rapidement la présence de moisissure noire. Simple d’utilisation, il est idéal pour les particuliers soucieux de leur environnement intérieur.

 En achetant ce produit, vous collectionnerez 40 points avec notre programme de fidélité. Vous pouvez convertir 40 points de votre compte en un bon pour un prochain achat.
En achetant ce produit, vous collectionnerez 40 points avec notre programme de fidélité. Vous pouvez convertir 40 points de votre compte en un bon pour un prochain achat.